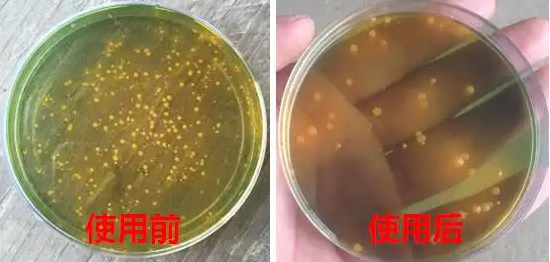
005.png

受天气影响,早晚温差大,而各地基层也普遍反馈,虾塘水浓白便、肠炎、弧菌超标现象多,难以控制,尤其是弧菌爆发一轮接一轮,刚压制下来不久,碰上一两天暴晒就又超标,不少塘口基本都无大规格活虾出塘,中小规格虾被弧菌感染最多。有养殖户表示,用了消毒剂起到的作用不大,又不敢用得多,怕影响对虾,但弧菌反反复复发作,上料都难,碰上有雨,倒藻清虾一条龙。
对虾弧菌病如何防治?
1稳水净底,降低盐度
水质调理不好,是万病的根源。弧菌最赖于生存的就是这恶劣的水质,倒藻、死藻沉入池底,弧菌栖息于此,严重危害了对虾的生存环境,另外对虾还可能摄食了一些藻类,导致对虾肝脏肠道被弧菌严重入侵,水质的调节就是要破坏弧菌赖以生存的环境,在灭杀弧菌必不可少。所以在养殖过程中定期进行改底操作,氧化底泥,偿还氧债,搭配补菌操作减少池塘有机物积累,可以有效的抑制弧菌的生长。

另一方面就是降低水体的盐度,高盐度的环境中弧菌更容易爆发;比如副溶血弧菌是海水弧菌又称嗜盐菌,盐度越低,其生长繁殖速度越慢。所以,有条件的可以在池塘中添加一些淡水,降低池塘的盐度以达到抑制副溶血弧菌繁殖和生长。
2免疫防治,护肝肠
提高免疫力方面可以从以下两方面入手,一方面则是使用一些发酵型饲料,也就是常说的“熟料”。一来可以减轻对虾胃肠的负担,增加吸收效果,提高机体抗病力;二来是也可降低粪便排出,饵料系数降低后,残饵粪便沉降到了池塘底部就变少,就避免陷入了因饲料吸收等问题引起的底部底臭,水质恶化的死循环,弧菌便无处遁形。另一方面就是使用免疫刺激物,具有激活酚氧化酶系统的作用,同时和虾青乳搭配,有效保护对虾肝胰腺,促进肝胰腺发育。提高血细胞的吞噬性及消化和杀死外来入侵微生物的能力,从而提高虾的免疫力。

3杀菌消毒,降低对虾感染风险
目前市面上有众多的杀菌产品如碘、过硫酸氢钾、二氧化氯、漂白粉等一些传统杀菌剂。碘对弧菌杀灭率不高;而过硫酸氢钾对比较柔和,且是第五代的杀菌产品,相对比较安全且效果比较好,但是其成本比较高;利用这些药物对弧菌都有较强的抑制作用,但也容易产生抗药性,同时也会加重对虾消化系统的负荷,容易造成对虾吃料减慢,出现肝肠疾病等。

消毒剂有刺激性,长期的使用传统的消毒剂,除了杀死有害细菌,还会杀死大量的有益菌和藻类,打破水体的生态平衡,使用不当的话,使对虾产生应激反应,趴边上草、不吃食等现象,重则会造成虾蟹伤亡。
建议养殖户使用抑菌抑菌、以菌吃菌的方式防治弧菌,更具有针对性,也比较安全。猎狐英雄可精准针对有害弧菌团猎杀,以菌吃菌,还有调理肠胃、清毒排毒和净化水质、稳定水色的功效。
猎弧英雄

精准针对有害弧菌团猎杀,以菌吃菌
猎弧英雄六大优势
1 本品采用精心挑选的日本进口噬菌蛭弧菌菌种,可以有效的裂解鱼虾蟹等危害各种养殖动物的各种弧菌属,(溶藻弧菌、副溶血弧菌,荧光弧菌,鳗弧菌),气单胞菌属,荧光单胞菌,点状单胞菌,大肠杆菌,发光杆菌等耐性原菌,裂解率高达95%以上。
2本品采用先进的生产工艺发酵,再经浓缩,喷雾干燥而成,具有菌群数量高,活性强、稳定易保存等优点,对各种常见致病菌均有极强的裂解能力,被称为“活性抗生素”,是代替抗生素等常规杀菌药物的换代产品。
3内含不同菌属蛭弧菌可通过识别并吸附宿主细菌,然后通过酶解和机械钻孔等一系列反应,进入到宿主细菌体内,终使宿主菌裂解死亡。可有效降低水体环境和动物体内的致病菌数量,维持菌相平衡,防控虾体红提,断须、红尾、烂眼等现象的发生。
4苗室育苗(鱼虾蟹海参等)过程中代替抗生素和消毒剂使用可防止抗生素苗等情况出现。与其他抗生素和化学消毒剂相比,猎弧英雄无任何刺激和残留,作用更持久,性能更稳定,无毒副作用,安全环保,是虾蟹、海参、黄鳝、甲鱼等特种养殖品种的明智选择。
5本品能明显减少水体耗氧量,降低水体中氨氮、亚硝酸盐等有害物质的产生,有效的分解海水中的发光弧菌,2-3天可有效的处理水体发光现象。净化水质、改良底质,改善水体富营养化的状况,稳定水质,保持良好的水体环境,杀菌效果还不受天气影响。
6安全且高效 ,菌体活化后生命力旺盛,主攻有害病原菌,高活性的蛭弧菌冻干粉,投入养殖水体后,立即以倍数繁殖成优势种群,能定向地清除、裂解有害致病菌,改良池塘水质和底质环境,对环境适应性强,环保安全,可以用鱼虾蟹养殖过程中的各个阶段均可使用。
用法1:将猎弧英雄化水后每瓶拌料100斤进行内服。若遇上弧菌急剧爆发,建议以猎弧英雄每瓶拌喂40斤饲料,连用三天,不仅可以“以菌杀菌”,防控因弧菌引发的白便、红体、偷死等情况,也可有效分解水体中的藻毒、粪便、氨氮、亚盐等有毒物质,效护理对虾肠胃、清毒排毒。
用法2:如果偷死情况较为严重,可用1瓶猎弧英雄拌喂10斤饲料与2斤小广州昆虫酶浆,每天一餐,连喂三天;外用泼水时,用量1瓶/亩。
用法3:也可以将猎弧英雄化水后,全池泼洒每瓶可用5-10亩/米,深水面,育苗每瓶可用100立方水。
提醒:“顺州牌”猎弧英雄采用日本进口噬菌蛭弧菌菌种,技术含量及有效性在同类产品中排名前列,但目前市面上出现不少效果极差的假冒伪劣产品或贴牌产品鱼目混珠,不仅技术含量低,且无论是对弧菌的吞噬杀灭效果还是在水体中的持续生效时间,都远低于合格线,同时也并未能起到“内服生效”的作用,建议养殖户注意辨别真伪。

| 发表评论 |
咨询:0779-2029779
随时,随地,伴你身边!
图文推荐
最新独家报道
今日要闻
热点推荐
X
